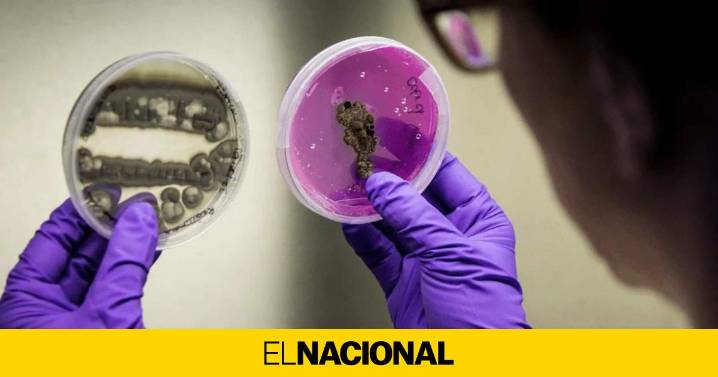
¿Quién forma el comité de seis expertos en bioseguridad que liderará la auditoría de la peste porcina?

Ya se conocen los nombres de los seis expertos en bioseguridad y peste porcina que formarán el comité que auditará las instalaciones, los equipamientos, los protocolos y los procedimientos para averiguar si el virus que ha provocado el brote en Catalunya ha salido de un laboratorio científico, y si es así, si está relacionado con el centro del IRTA-CReSA o los laboratorios próximos a la zona cero donde se encontraron los primeros casos, en Cerdanyola del Vallès. El consejero de Agricultura, Ganadería, Pesca y Alimentación de la Generalitat, Òscar Ordeig, ha anunciado la composición de este comité de especialistas, que estará coordinado por el director del IRTA, Josep Usall, y que estará formado por la doctora Laura Pérez, jefa del área animal y seguridad biológica del CISA (Cen
¿Quién forma el comité de seis expertos en bioseguridad que liderará la auditoría de la peste porcina?
El Nacional.cat3 hrs ago
116


El Periódico Extremadura
La Vanguardia España
Noticias de España
ALERTA El Diario de Cantabria
ElDiario.es Internacional
The Conversation Español
Cadena SER